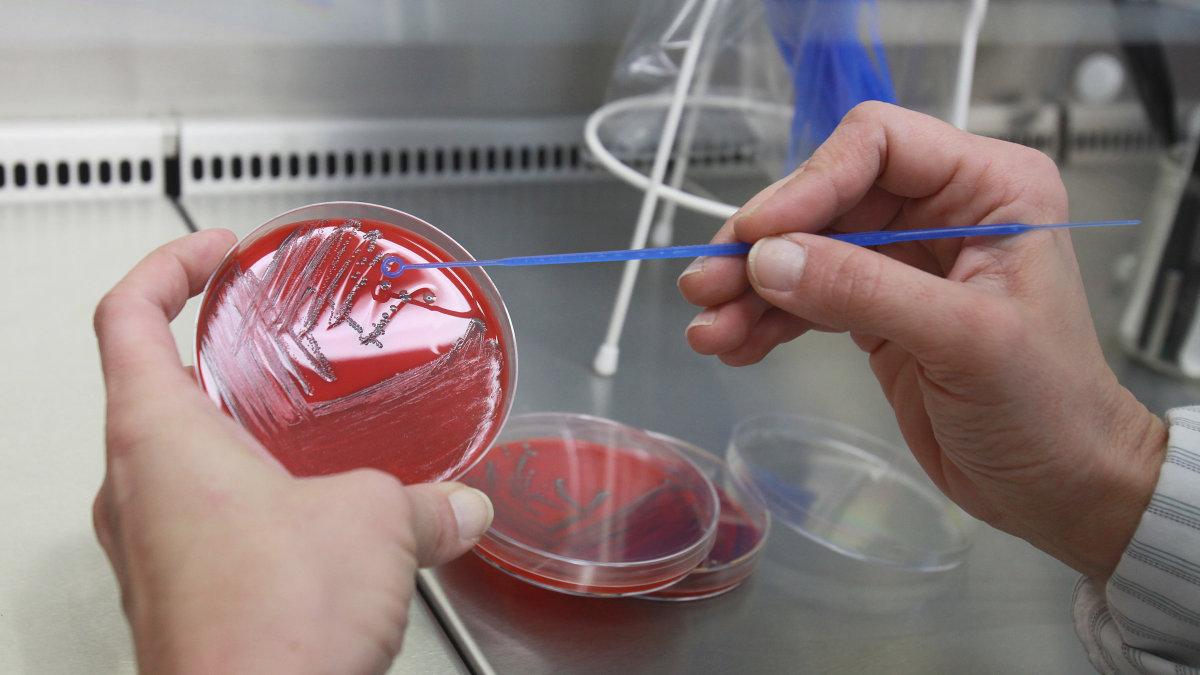
Wie man sich vor Listerien schützt

Listerien (ausgesprochen als /ˌlɪsˈteːʀi̯ən/) sind stäbchenförmige, 0,4–0,5 µm × 0,5–2 µm große, grampositive, nicht endosporenbildende, fakultativ anaerobe Bakterien der Gattung Listeria, benannt nach dem britischen Chirurgen Joseph Lister. Sie sind peritrich begeißelt und können sich somit durch Schwimmen aktiv fortbewegen.
Wachstum
Listerien sind anspruchslos. Sie können sich in nährstoffarmen Substraten (Wasserpfützen, Kondenswasser) vermehren. Das optimale Wachstum erzielen sie im Temperaturbereich von 30 bis 37 °C, in einem pH-Bereich von 5,0 bis 9,0 und einer etwas erhöhten Kohlenstoffdioxidkonzentration. Sie sind aber auch im erweiterten Temperaturbereich von 4 bis 45 °C überlebens- und wachstumsfähig. Die Tatsache, dass sie kältetolerant (psychrotolerant) sind, sowie ihre Fähigkeit, vom aeroben Stoffwechsel in einen anaeroben zu wechseln, ermöglicht es ihnen, sich auch in vakuumverpackten Lebensmitteln (Fleischprodukte, Rohmilch, Käse, Räucherfisch), die im Kühlschrank liegen, zu vermehren.
Natürliches Vorkommen
Listerien sind in der Natur nahezu ubiquitär (allgegenwärtig) verbreitet und ernähren sich von totem organischen Material (Saprobier). Man trifft sie sowohl auf pflanzlichen Materialien an – zum Beispiel auf abgestorbenen Gräsern und im Kopfpolsterstaub – als auch im Darmtrakt von Menschen und Tieren. Schätzungsweise ein bis zehn Prozent der Menschen tragen Listerien im Darm und scheiden sie mit dem Stuhl aus.
Pathogenität
Listerien können die meldepflichtige Infektionskrankheit Listeriose verursachen, die bei Infektion durch die Art Listeria monocytogenes auch humanpathogen ist. Letztere erfolgt durch die Aufnahme kontaminierter Nahrung, bei Tieren (hauptsächlich Rind und Schaf) durch ungenügend angesäuerte Silage, beim Menschen durch den Verzehr von nicht sachgerecht hergestellten Lebensmitteln (vor allem Fleisch-, Fisch- und Milchprodukte). Listerien sind vor allem in nicht erhitzten tierischen Lebensmitteln (zum Beispiel in Rohmilch und in nicht erhitztem Rohmilchkäse) enthalten. Pflanzliche Lebensmittel sind im Allgemeinen weniger betroffen, Listerien können jedoch durch Düngung mit tierischem Abwasser (Jauche) auf Gemüse gelangen. Sie finden sich auch häufiger in küchenfertig abgepackten Salaten.
Lebensmittelsicherheit
Obwohl Listerien fast überall sind, ist die Zahl der nachgewiesenen Erkrankungen überraschend niedrig (für 2018 in Deutschland 698 Meldungen). Das könnte am üblicherweise geringen Gehalt an Listeria monocytogenes in Lebensmitteln liegen (unter 100 Bakterien je Gramm), eher aber an deren schwieriger Nachweisbarkeit. Zudem könnte es daran liegen, dass die Erkrankung manchmal erst Wochen später mit unspezifischen Symptomen wie Fieber und Durchfall ausbricht. Durch die zunehmende industrielle Produktion von Lebensmitteln mit ihren vielen Zwischenstufen erhöht sich die Zahl der Kontaminationsmöglichkeiten. Dem versucht man durch entsprechende Hygienemaßnahmen zu begegnen. Hin und wieder kommt es dennoch zu Rückrufaktionen wegen Listerien. Anfang November 2019 mussten z. B. Rewe und Norma bestimmte Frikadellenbällchen wegen eines Listerienverdachts zurückrufen. Anfang 2021 mussten in der Schweiz von Migros, Denner, Aldi Suisse und Lidl verschiedene Fertigsalate wegen Listerien auf Maiskörnern zurückgerufen werden. Anfang 2023 musste Netto bestimmte Fertigsalate wegen Befall mit Listeria monocytogenes zurückrufen. 2024 musste bei Rewe und Edeka ein Produktrückruf von Käse des Herstellers Sarzbüttel erfolgen.
Klinik
Eine Listeriose verläuft bei gesunden Menschen meist harmlos oder wird sogar kaum bemerkt. Werden besonders viele Erreger aufgenommen, kann es zu Fieber und Durchfällen kommen. Kleinkinder oder Menschen mit geschwächter Immunabwehr, wie frisch Operierte, Aids- oder Krebspatienten und Diabetiker können schwer erkranken.
Der Ausbruch der Erkrankung kann bis zu acht Wochen nach Aufnahme der Bakterien erfolgen. Listerien können Septitiden („Blutvergiftungen“) oder Meningitiden (Hirnhautentzündungen) verursachen, die mit Antibiotika behandelt werden können, aber dennoch in 30 Prozent der Fälle zum Tode führen.
Besonders bei Schwangeren ist eine Listeriose sehr gefährlich, da sie fatale Folgen für das ungeborene Kind haben kann. Es kann zu Frühgeburt, schweren Schädigungen oder sogar zum Absterben des Fötus kommen. Die Schwangere hingegen bemerkt die Erkrankung oft nicht einmal.
Therapie
Ist eine Listeriose durch den Nachweis der Erreger diagnostiziert, wird der Betroffene mit Antibiotika behandelt. In 70 Prozent der Fälle kann so die Erkrankung gestoppt werden. Die Meningitis durch Listeria monocytogenes wird mit Aminopenicillinen (Ampicillin oder Amoxicillin), eventuell in Kombination mit Aminoglycosiden (Gentamicin) behandelt. Der direkte Nachweis der Listerien in Blut, Liquor cerebrospinalis oder Eiter gelingt nicht immer. Andere Testverfahren, wie etwa der Nachweis von Antikörpern im Blut, sind andererseits untauglich. Daraus folgt, dass viele Erkrankungen gar nicht erkannt werden.
Genomforschung
Im Jahr 2001 wurden im Rahmen eines von der EU finanzierten Forschungsprojektes die kompletten DNA-Basensequenzen des Genoms von Listeria monocytogenes und von Listeria innocua ermittelt, veröffentlicht und aus dem Vergleich der Daten umfangreiche neue Erkenntnisse über die Biologie und Evolution der Bakterien abgeleitet. Von den anderen Mitgliedern der Gattung Listeria werden gegenwärtig ebenfalls die DNA-Basensequenzen des kompletten Genoms ermittelt.
Publizierte Genomsequenzen:
- L. monocytogenes Sv1/2a
- L. innocua Sv6a
- L. monocytogenes Sv4b F2365
- L. monocytogenes Sv4b H7858, 178 contigs
- L. monocytogenes Sv1/2a F6854, 133 contigs
Ermittelte, aber noch nicht publizierte Genomsequenzen:
- L. welshimeri Sv6b
- L. seeligeri Sv1/2b
- L. monocytogenes Sv4a
- L. monocytogenes Sv4b
- L. ivanovii Sv5
Literatur
- P. Glaser, L. Frangeul u. a.: Comparative genomics of Listeria species. In: Science. Band 294, Nummer 5543, Oktober 2001, S. 849–852, ISSN 0036-8075. doi:10.1126/science.1063447. PMID 11679669.
- J. A. Vázquez-Boland, M. Kuhn u. a.: Listeria pathogenesis and molecular virulence determinants. In: Clinical microbiology reviews. Band 14, Nummer 3, Juli 2001, S. 584–640, ISSN 0893-8512. doi:10.1128/CMR.14.3.584-640.2001. PMID 11432815. PMC 88991 (freier Volltext). (Review).
- M. Korthals, M. Ege u. a.: Occurrence of Listeria spp. in mattress dust of farm children in Bavaria. In: Environmental Research. Band 107, Nummer 3, Juli 2008, S. 299–304, ISSN 1096-0953. doi:10.1016/j.envres.2008.02.007. PMID 18377890.
Weblinks
- Robert Koch-Institut (RKI): Ausbrüche und nähere Infos zu Listeriose
- Informationen zu Listerien in Lebensmitteln. Bayerisches Staatsministerium der Justiz und für Verbraucherschutz
- Jean Euzéby, Aidan C. Parte: Genus Listeria. In: List of Prokaryotic names with Standing in Nomenclature (LPSN). Abgerufen am 4. Januar 2014.
- Klaus Höfler, Jürgen Langenbach: Sechs Todesfälle nach Bakterien in steirischem Käse diepresse.com, 16. Februar 2010, abgerufen am 21. November 2019.
- Bundesinstitut für Risikobewertung (BfR): Verbrauchertipps: Schutz vor Lebensmittelinfektionen mit Listerien
Einzelnachweise